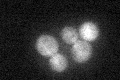
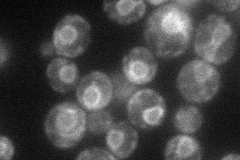
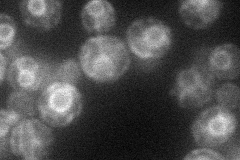
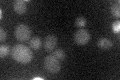

View description
Protein that interacts specifically in vivo with phospholipid translocase (flippase) Dnf3p; similar to Cdc50p, which is an essential interaction partner of the flippase Drs2p
Localization:
Intensity:
Fold change:
Significance:
-
C’ GFP library in SD
cytosol24.73 -
N' NOP1pr-GFP in SD
ER55.3175 -
N' TEF2pr-mCherry in SD
ER28.8634 -
N' NATIVEpr-GFP in SD

ER28.2488 -
N' TEF2pr-VC and Cyto-VN in SD

below threshold24.9535 -
C’ GFP library in SD+DTT

cytosol16.370.66No -
C’ GFP library in SD+H2O2

cytosol20.350.82No -
C’ GFP library in Starvation Media
cytosol21.560.87No -
C’ GFP library on the background of Pup2-DaMP

cytosol -
C’ GFP library on the background of CCT mutant

cytosol22.4420.907026No
